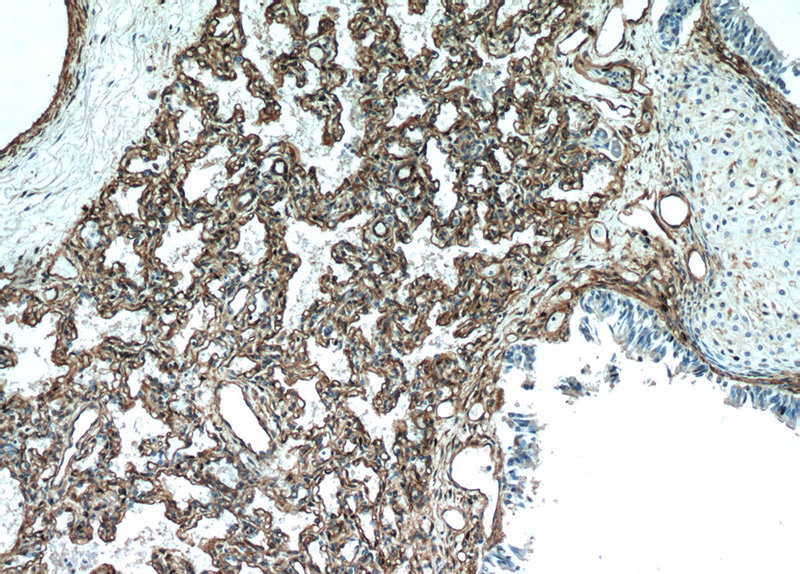
Immunohistochemical of paraffin-embedded human lung using Catalog No:108895(CAV1 antibody) at dilution of 1:50 (under 10x lens)

-
Product Name
Caveolin-1 antibody
- Documents
-
Description
Caveolin-1 Rabbit Polyclonal antibody. Positive IP detected in A549 cells. Positive WB detected in A549 cells, mouse large intestine tissue, NIH/3T3 cells, rat colon tissue. Positive IHC detected in human lung tissue, human heart tissue. Observed molecular weight by Western-blot: 20-25kd
-
Tested applications
ELISA, WB, IHC, IP
-
Species reactivity
Human,Mouse,Rat; other species not tested.
-
Alternative names
BSCL3 antibody; CAV antibody; CAV1 antibody; Caveolin 1 antibody; CGL3 antibody; MSTP085 antibody; VIP21 antibody
-
Isotype
Rabbit IgG
-
Preparation
This antibody was obtained by immunization of Caveolin-1 recombinant protein (Accession Number: BC006432). Purification method: Antigen affinity purified.
-
Clonality
Polyclonal
-
Formulation
PBS with 0.02% sodium azide and 50% glycerol pH 7.3.
-
Storage instructions
Store at -20℃. DO NOT ALIQUOT
-
Applications
Recommended Dilution:
WB: 1:500-1:5000
IP: 1:200-1:2000
IHC: 1:20-1:200
-
Validations

A549 cells were subjected to SDS PAGE followed by western blot with Catalog No:108895(CAV1 antibody) at dilution of 1:300
Immunohistochemical of paraffin-embedded human lung using Catalog No:108895(CAV1 antibody) at dilution of 1:50 (under 10x lens)

Immunohistochemical of paraffin-embedded human lung using Catalog No:108895(CAV1 antibody) at dilution of 1:50 (under 40x lens)

IP Result of anti-Caveolin-1 (IP:Catalog No:108895, 3ug; Detection:Catalog No:108895 1:500) with A549 cells lysate 1200ug.
-
Background
Caveolin-1 (CAV1), a multifunctional protein, is the main constituent molecule of caveolae and represents a scaffolding molecule for several signaling molecules including epidermal growth factor receptor (PMID: 19641024). Several studies have implicated that a reduced expression of CAV1 was found in cancers including head and neck carcinoma (PMID: 19002186). However, other studies recognize CAV1 as a tumor promoter because CAV1 is overexpressed in various kinds of cancers, especially in oral cancer (PMID: 20558341). Recent study also show that CAV1 is involved in astric Cancer (PMID: 25339030).
-
References
- Miao L, Xiong X, Lin Y. miR-203 inhibits tumor cell migration and invasion via caveolin-1 in pancreatic cancer cells. Oncology letters. 7(3):658-662. 2014.
- Li B, Zhang Z, Zhang H. Aberrant miR199a-5p/caveolin1/PPARα axis in hepatic steatosis. Journal of molecular endocrinology. 53(3):393-403. 2014.
- Huang CF, Yu GT, Wang WM, Liu B, Sun ZJ. Prognostic and predictive values of SPP1, PAI and caveolin-1 in patients with oral squamous cell carcinoma. International journal of clinical and experimental pathology. 7(9):6032-9. 2014.
- Zhu Z, Tan Z, Li Y. Docosahexaenoic acid alters Gsα localization in lipid raft and potentiates adenylate cyclase. Nutrition (Burbank, Los Angeles County, Calif.). 31(7-8):1025-30. 2015.
- Guo D, Liang S, Wang S. Role of epithelial Na+ channels in endothelial function. Journal of cell science. 129(2):290-7. 2016.
Related Products / Services
Please note: All products are "FOR RESEARCH USE ONLY AND ARE NOT INTENDED FOR DIAGNOSTIC OR THERAPEUTIC USE"
